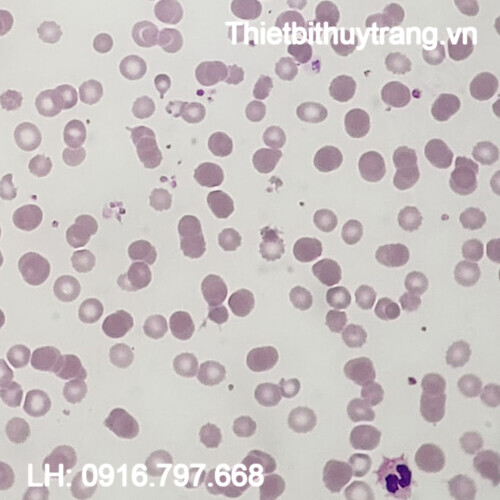

VPGD: Số 2A, ngõ 39, đường Tú Mỡ, phường Trung Hoà, quận Cầu Giấy, Tp.Hà Nội
Giờ làm việc: 08h – 17h30 (từ thứ 2 đến thứ 7)
Hotline: 0916.797.668
Email: kinhdoanhthuytrang@gmail.com
Sản phẩm chính hãng
Rõ ràng nguồn gốc xuất xứ, bảo đảm chất lượng, bảo hành theo chính sách của nhà sản xuất.Giá cả cạnh tranh nhất
Chúng tôi cam kết giá bán tốt nhấtGiao hàng nhanh toàn quốc
Giao hàng tận nơi với thời gian ngắn nhất, chi phí thấp nhấtĐầy đủ hóa đơn, chứng từ
Sản phẩm nhập khẩu chính hãng, đầy đủ hóa đơn, chứng từ, CO/CQ.
Từ khóa: